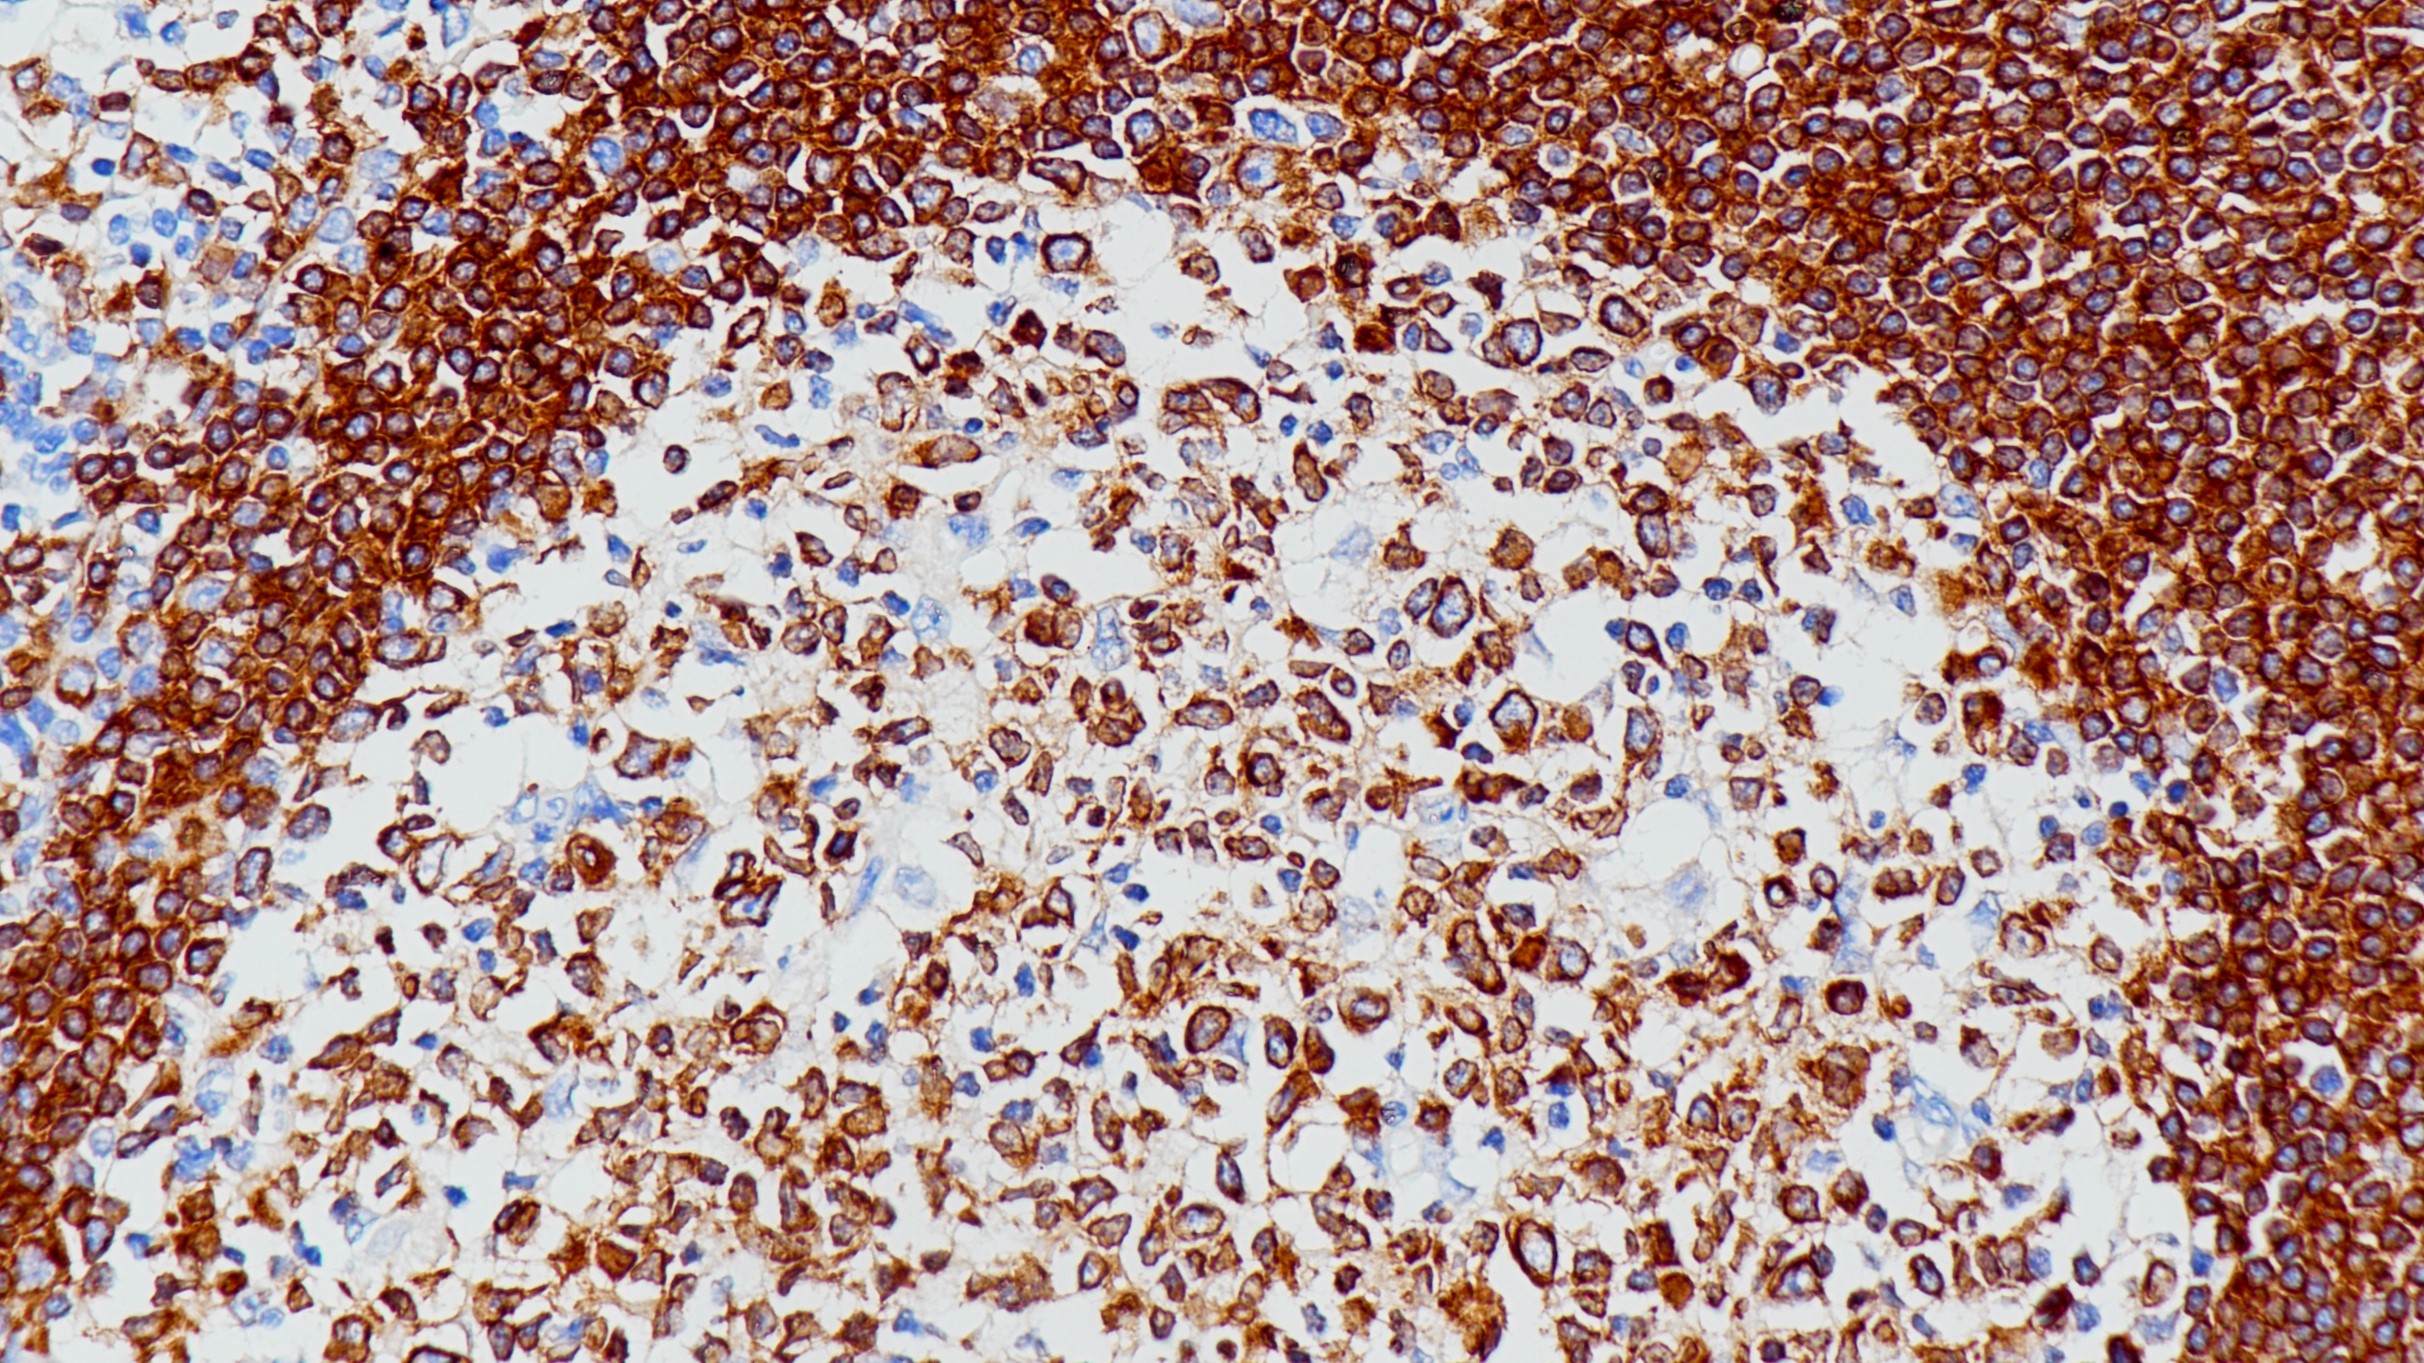
扁桃体CD79a(BP6040)染色

1. Kanavaros P, Gaulard P, Charlotte F, et al.. American Journal of Pathology. 146 (3): 735–741 (1995).
2. van Noesel C J M, Brouns G S, van Schijndel G M W, et al.. Journal of Experimental Medicine. 175: 1511–1519 (1992).
3. 中华医学会.《临床技术操作规范·病理学分册》.人民军医出版社,2004.